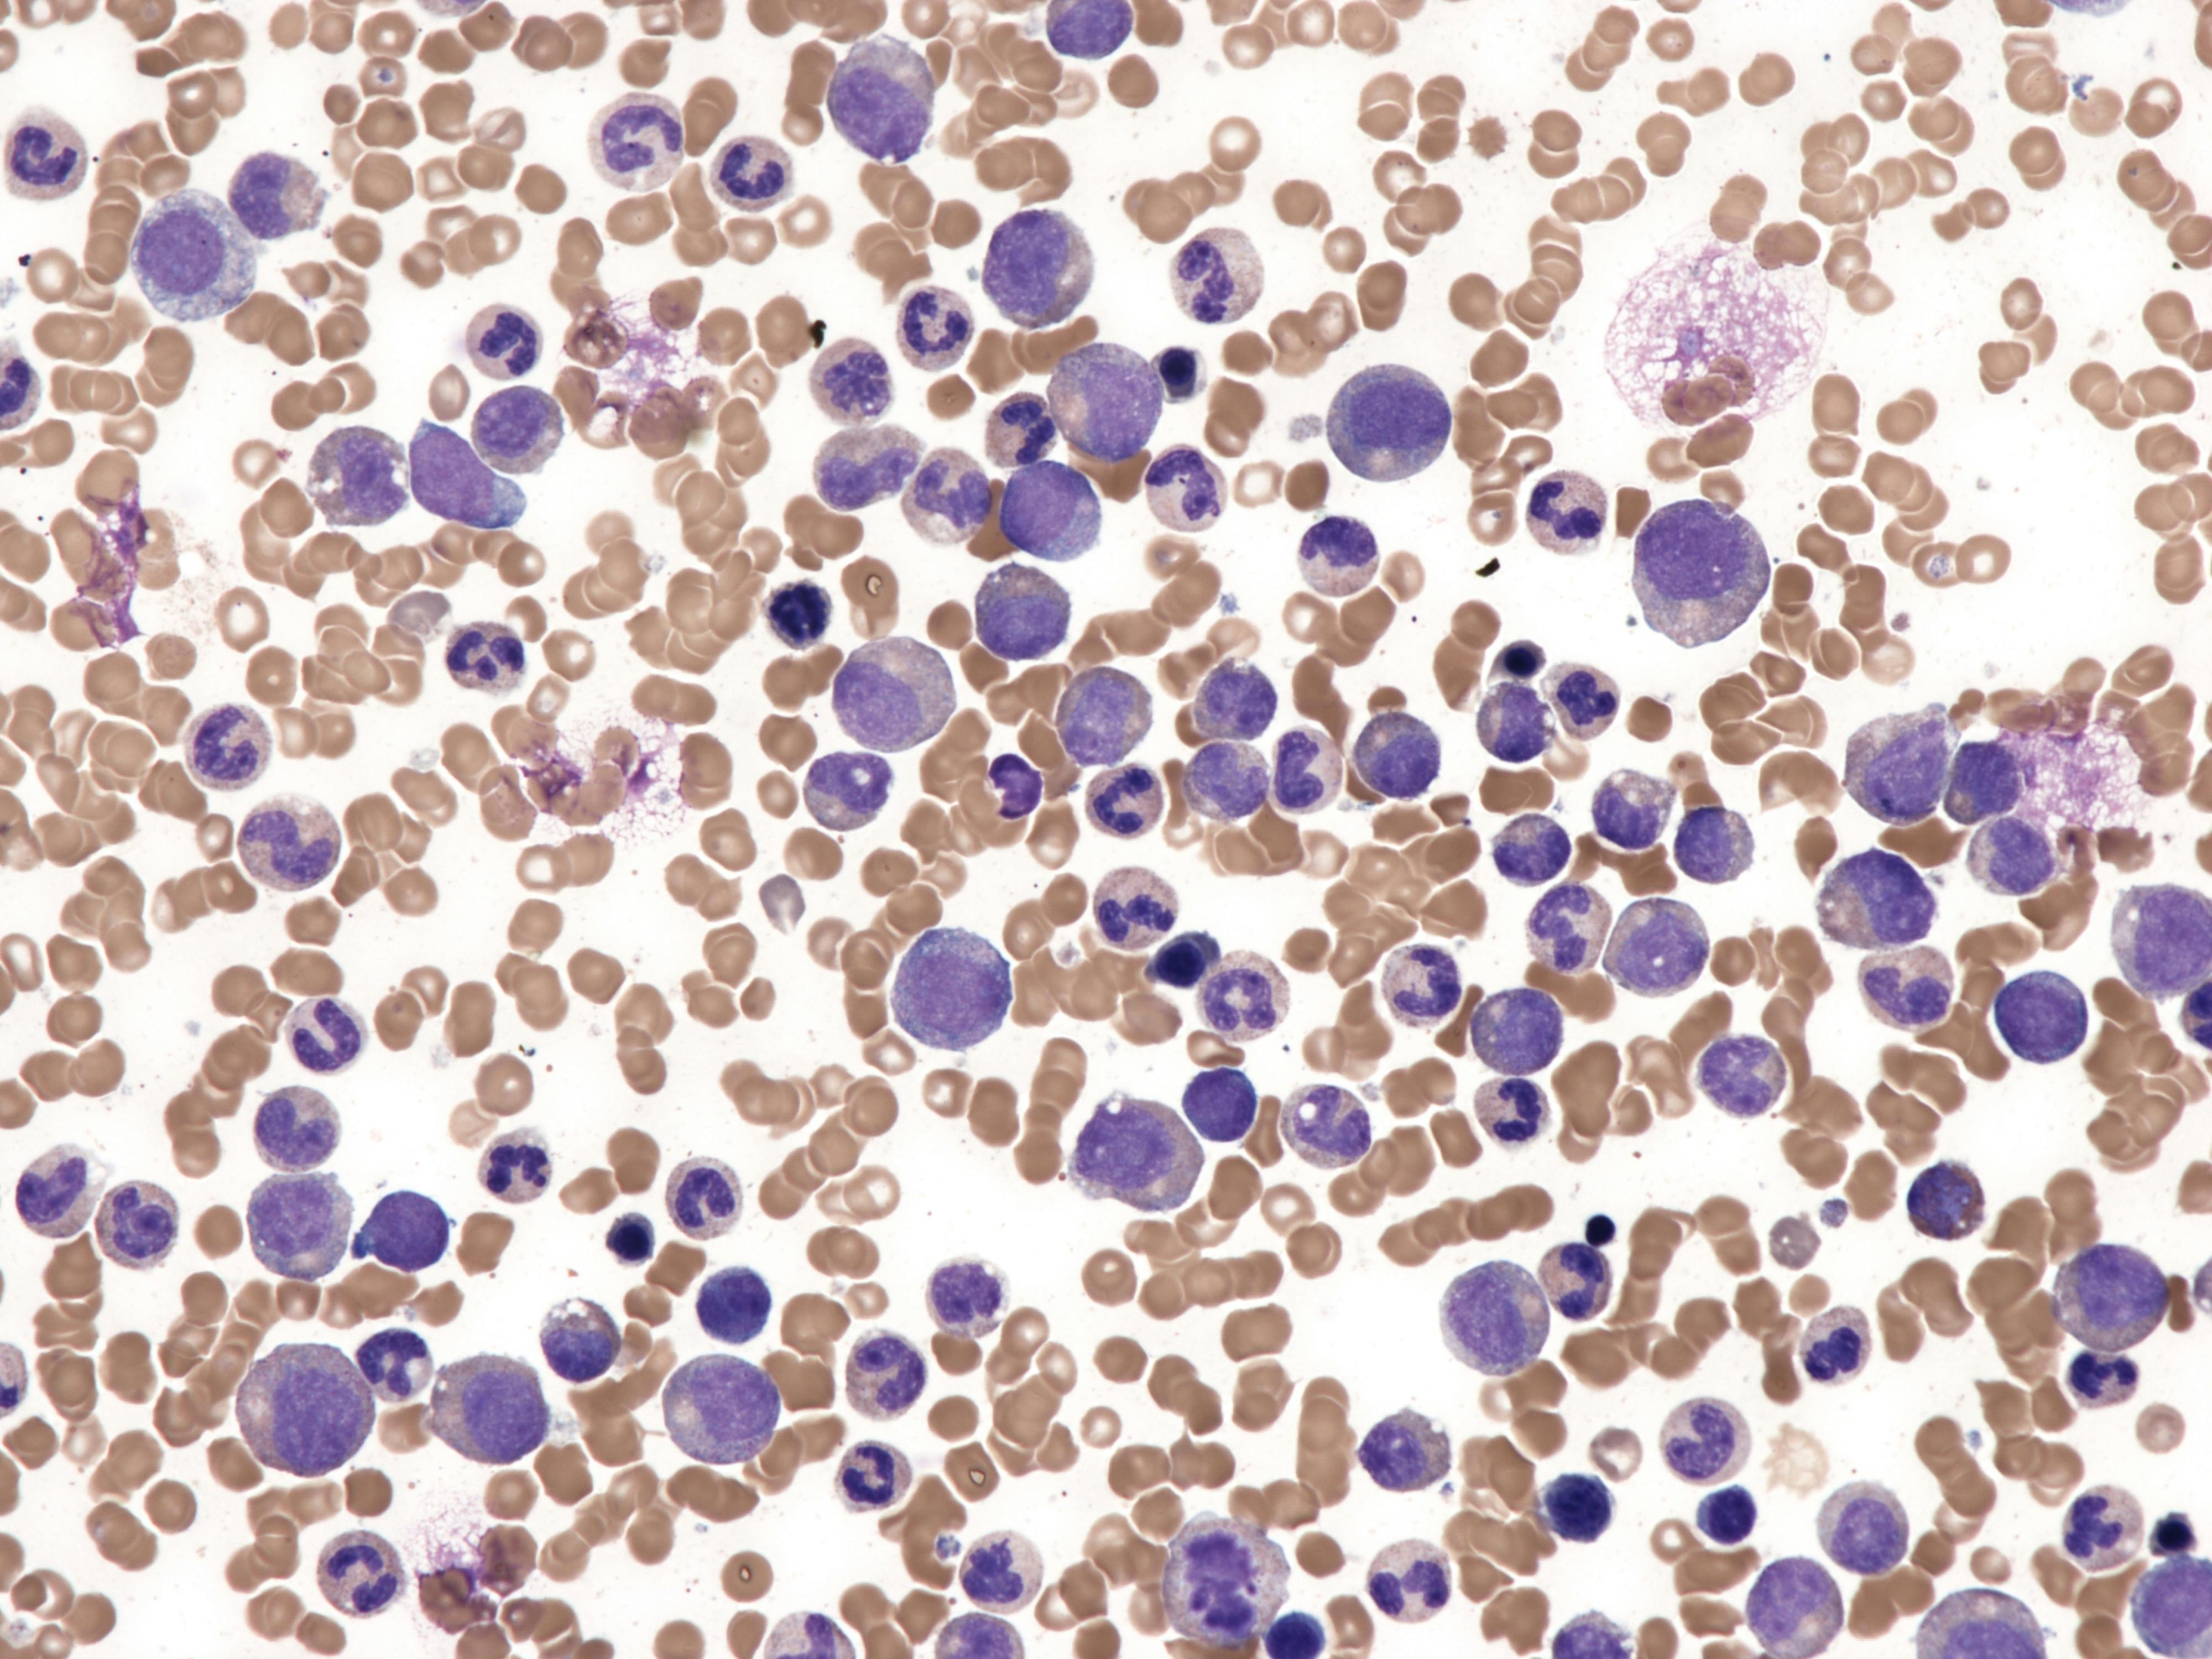
68e675e7eaa70bc21775ddae Dreamstime Xxl 372428619

Updates to the approach pathologists use to classify myelodysplastic neoplasm (MDS), formally known as myelodysplastic syndrome, are expected to improve treatment decision-making for patients, according to a new publication by the College of American Pathologists (CAP).
Pathologists on the CAP Personalized Health Care Committee examined the new World Health Organization 5th Edition (WHO5) classification and International Consensus Classification (ICC), together with changes to the Molecular International Prognostic Scoring System (IPSS-M), that redefined MDS by precisely identifying disease subtypes and individual risk. These updates will enable physicians to make more accurate diagnoses and provide personalized treatments.
Key updates:
- Genetically defined subtypes: TP53-mutated, SF3B1-mutated, and del(5q) MDS now formally recognized.
- Different approaches: WHO5 requires dysplasia, while ICC allows certain genetic lesions to define MDS without it.
- Risk stratification advances: The IPSS-M integrates molecular and clinical data, outperforming prior scoring systems and refining treatment pathways.
- Future direction: Emerging molecular taxonomy will supplement morphology-based diagnosis systems.
About the Author
Sign up for our eNewsletters
Get the latest news and updates